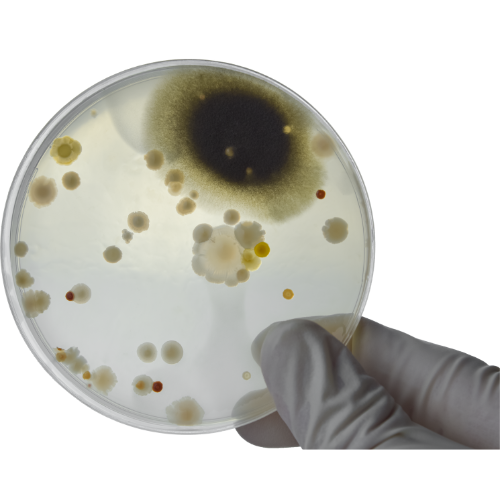

Mold Inspection & Air Testing

Mold Inspection & Air Testing Services of Oak Island, NC.
Professional mold inspections and air quality testing are designed to locate all areas with mold growth present and to determine the level of mold contamination affecting the safety of interior air and surfaces. This form of testing provides the feedback needed for Remediation Solutions to create a proper mold remediation and prevention plan. Mold and air testing methods require professional expertise and equipment.

Comprehensive Mold Inspection: Identifying and Testing for Contamination
Our inspection process begins with a thorough physical inspection of a building’s crawl space, walls, ceilings, ductwork, and other interior spaces to establish an initial finding as to the level and extent of any mold infestation. When needed, surface samples are taken from structures suspected of being contaminated for laboratory testing.
Understanding Air Testing: Identifying Mold Spores and Assessing Health Risks
Air testing involves taking appropriate samples for us to test. Airborne mold spores are not visible, and testing is necessary to determine what types of mold spores are present in the air inside a building. Air testing provides information regarding the scope and severity of mold infestation and assists in determining the hazards to human health that are present.


Comprehensive Air Testing: Detecting Mold and Harmful Bacteria in Your Home
In addition to testing for mold contamination, our professional air tests check for bacteria. Bacteria grow and multiply rapidly, and many harmful bacteria can be found in interior air. Dangerous airborne bacteria are typically found when interior spaces have been contaminated with sewage or black water.
Understanding Volatile Organic Compounds: The Hidden Impact on Indoor Air Quality
Air testing also includes checking the air for volatile organic compounds. These chemicals are gases generated from manufactured materials that are organic and can be highly toxic to humans under certain conditions. When indoor air space is poorly ventilated, and volatile organic compounds are present, air quality can be significantly affected. Manufactured furniture, electronics, paints, glues, and many other commercial products have the potential to emit volatile organic compounds into interior air spaces.


Ensuring Optimal Air Conditions: Preventing Mold Growth with Comprehensive Temperature Testing
Our testing process also checks air temperatures throughout all interior spaces. Areas that are not adequately air-conditioned can maintain elevated temperatures in warm weather. Warm air stores more moisture and is conducive to mold growth in higher levels than relatively cooler air circulating through an HVAC system.
Precision Moisture Testing: Key to Mold Prevention and Control
Remediation Solutions also tests humidity and moisture content in wooden structures and surfaces prone to mold growth. It is virtually impossible to destroy every existing mold spore inside a building, and moisture control is the key to eliminating suitable mold habitat. We use professional moisture meters to locate areas with excess moisture with exact precision. Modern testing can reveal areas where water is intruding, and leaks that foster mold growth.


Post-Remediation Inspection and Testing for Complete Mold Remediation and Moisture Control
Following any remediation treatments or other preventative steps, follow-up inspection and testing will determine whether additional steps are needed for complete mold remediation and prevention. Any remediation related to drainage and water control is also inspected and tested to ensure that the moisture control plan is working correctly.
Remediation Solutions can provide a free estimate for inspecting and testing any residential or commercial property for surface and airborne mold infestation. Call today to ensure the safety and well-being of you and your family.
Contact us to schedule an appointment!

